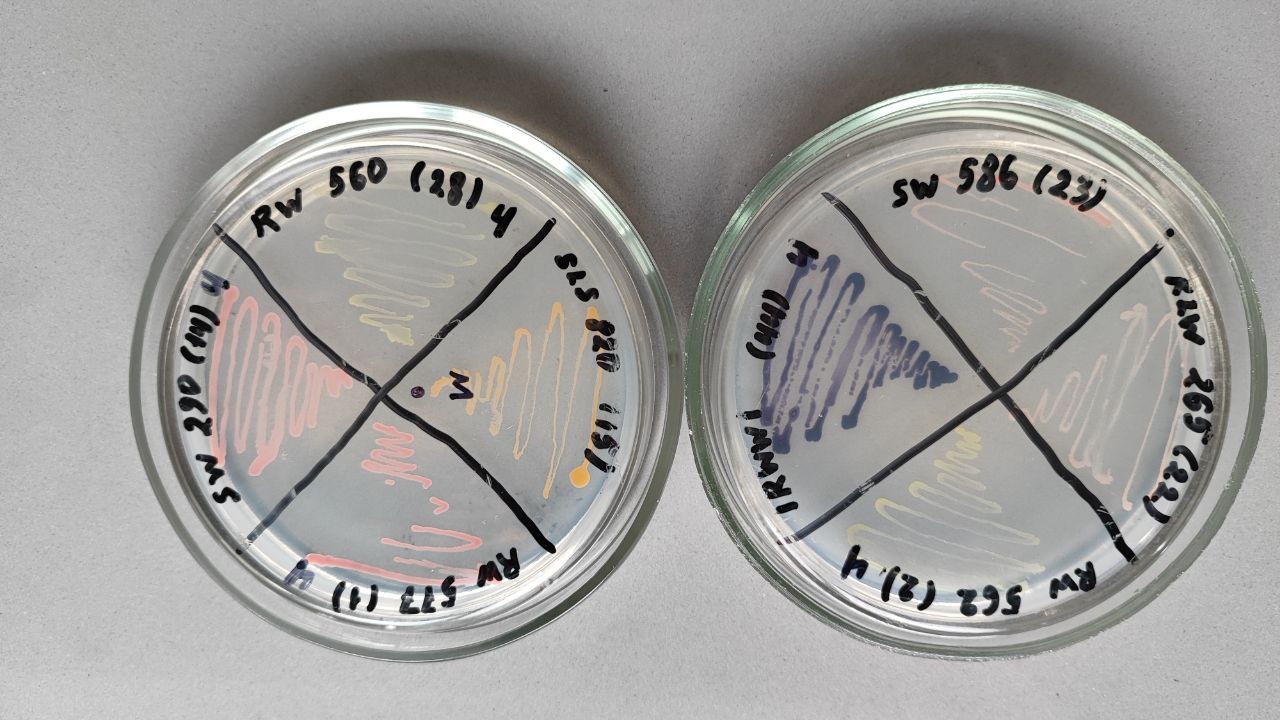
Photo 3

18 ноября в наш Институт посетили ученики 11 класса Вальдорфской школы. Ребята интересуются биологией и хотели увидеть внутреннее строение клеток с помощью электронных микроскопов. Экскурсию по центру коллективного пользования "Электронная микроскопия" провели д.б.н., проф. Игорь Викторович Клименков и к.б.н. Мария Башенхаева. Ребята узнали, как проходит подготовка ультратонких срезов для просвечивающего микроскопа; посмотрели на митохондрии в разрезе; на бактериофагов, атакующих клетку; как происходит инфаркт у мыши и кто входит в состав фитопланктона Байкала.
Кроме микроскопов школьникам показали с помощью какого оборудования ученые отбирают пробы воды и фитопланктона; рассказали в каких лабораторных условиях комфортно жить байкальским микроводорослям и почему бактерии бывают разноцветные. Экскурсия прошла оживлённо и заинтересованно, ребята задавали вопросы, смотрели в микроскоп и проявили желание посетить другие лаборатории нашего Института в следующий раз. И возможно в будущем, кто-то из них тоже выберет увлекательный путь исследователя!